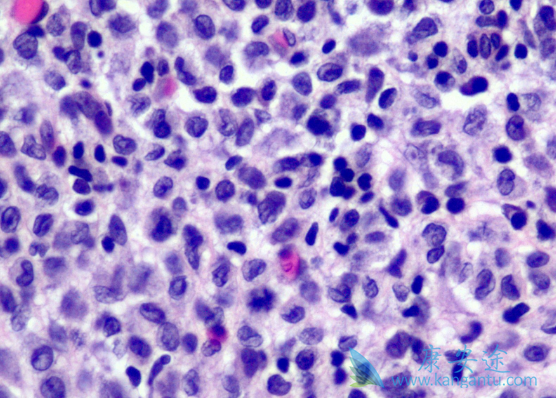
޷

Erdheim-Chester 病(ECD)为一种罕见的非朗格罕组织细胞增生症,其中心脏与神经系统受累,与死亡率与发病率的显着增加相关。研究显示超过一半的 ECD 患者有 BRAFV600E 突变。威罗菲尼(Vemurafenib),是一种选择性低分子量 BRAF 激酶抑制剂,可以选择性抑制表达 BRAFV600E 突变蛋白的肿瘤细胞增殖,对转移性黑色素瘤(包括脑内转移)有效。
有研究显示,威罗菲尼对 3 名 ECD 伴 BRAF 突变患者高度有效。而本文报道了一例威罗菲尼有效治疗鞍上病变压缩视交叉神经导致视力减退的 ECD 患者。但这是一个单一的观察性研究,没有对照试验。在病人签署知情同意书后,开始使用威罗菲尼片治疗,具体剂量为 480mg(每天 2 次)。在第十天,两侧视力改善(左眼:0.7 升至 1.0;右眼:0.8 升至 1.0);双侧视野正常。通过 PET以及脑 MRI 对患者重新进行评估。PET 显示鞍上仅存有轻微残留;肺代谢亢进;MRI 检测显示肿瘤尺寸降低。最后在治疗期间没有副作用。
本次病例提示,BRAF 抑制治疗对中枢神经浸润性 ECD 患者有效。患者视力以及视野显着改善,并且快速回到正常水平。因此抑制 BRAF 激酶突变的药物,有可能成为威胁生命性 ECD 的一线治疗药物。尽管威罗菲尼(Vemurafenib)良好耐受;但仍应该考虑安全问题;尤其是长期治疗的效果。今后应该进一步评估 BRAF 抑制剂长期治疗的预后。
详情请访问 肿瘤 http://www.kangantu.org/
















请简单描述您的疾病情况,我们会有专业的医学博士免费为您解答问题(24小时内进行电话回访)